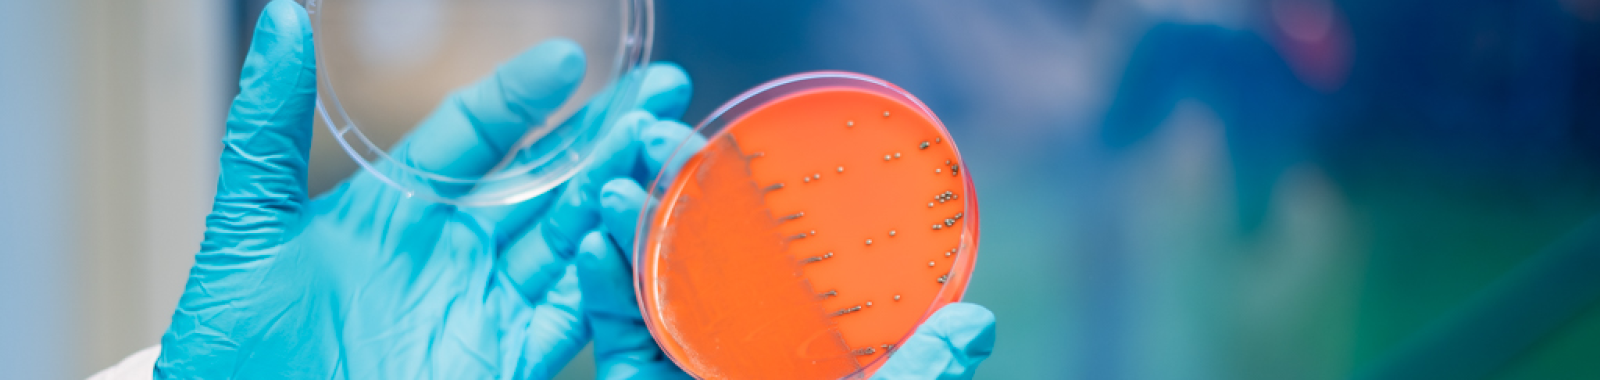

Proficiency Testing/ Certified Reference Materials
PT Microbiology
Proficiency Testing (PT) is an external quality control that evaluates the laboratory’s ability to analyze and report accurate results over time. Participating laboratories will have their performance assessed by Eurofins, an independent accredited provider, allowing them also to compare their results and methods with those of other laboratories worldwide. Our PTs are excellent to simulate real life samples.
PT Microbiology →CRM Microbiology
Certified Reference materials (CRMs) are used as internal controls. Each CRM is accompanied by a certificate that indicates the level of target organisms, and the laboratory will independently assess whether the results are satisfactory. CRMs are excellent for training new staff and monitoring everyday quality.
CRM Microbiology →Accredited reference materials
PT samples and CRMs are produced accredited by IFM Quality Services. The production complies with the requirements of ISO/IEC 17034; General requirements for the competence of reference material producers.
PT vs CRM
The participation in PTs and the use of CRMs can complement each other to meet the requirements of ISO/IEC 17025 ensuring validity of results and metrological traceability. They can serve many of the same purposes, however there are areas where one may be more suitable than the other. Some examples are provided below.

Contact
Nina Skammelsrud
SLP Leder/PT Manager
+47 481 80 117
PT001@ftn.eurofins.com
Therese Lundberg
SLP koordinator/PT Coordinator
+47 958 02 652
PT001@ftn.eurofins.com